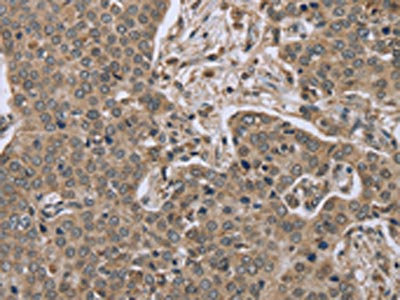
CSB-PA971812

IL15RA
IL15RA,即白細胞介素15受體α,別名CD215、IL 15R alpha、IL-15 receptor subunit alpha。它是一種由IL15RA基因編碼的蛋白質,屬于I型細胞因子受體家族成員,主要在多種免疫細胞表面表達,如T細胞、自然殺傷(NK)細胞、自然殺傷T細胞(NKT)、樹突細胞和單核細胞等。IL15RA的作用機制主要是通過與IL-15結合,形成異源二聚體與IL-2/IL-15Rβ-γc受體復合體,進而激活JAK/STAT、PI3K/AKT、mTOR等下游信號通路,促進免疫細胞的存活、增殖和分化。IL15RA參與調節免疫細胞的發育、功能和穩態。IL15RA的表達對于NK細胞、NKT細胞和記憶性CD8+ T細胞的存活和功能至關重要。此外,IL15RA還參與調控炎癥反應和抗腫瘤免疫,其異常表達或功能失調與某些疾病有關,包括某些類型的癌癥和自身免疫性疾病。因此,IL15RA是免疫學研究和相關疾病治療中的一個潛在靶點。
熱銷產品
Recombinant Human Interleukin-15 receptor subunit alpha (IL15RA), partial (CSB-MP614402HU)
驗證數據

(Tris-Glycine gel) Discontinuous SDS-PAGE (reduced) with 5% enrichment gel and 15% separation gel.

The purity of IL15RA was greater than 90% as determined by SEC-HPLC
IL15RA Antibody (CSB-PA971812)
驗證數據
The image on the left is immunohistochemistry of paraffin-embedded Human liver cancer tissue using CSB-PA971812(IL15RA Antibody) at dilution 1/45, on the right is treated with synthetic peptide. (Original magnification: ×200)

The image on the left is immunohistochemistry of paraffin-embedded Human lung cancer tissue using CSB-PA971812(IL15RA Antibody) at dilution 1/45, on the right is treated with synthetic peptide. (Original magnification: ×200)
Human Interleukin-15 receptor subunit alpha(IL15RA) ELISA kit (CSB-EL011594HU)
驗證數據

貨號:CSB-EL011594HU
規格:96T/48T
靈敏度:7.8 pg/mL
檢測范圍:31.25 pg/mL-2000 pg/mL
These standard curves are provided for demonstration only. A standard curve should be generated for each set of samples assayed.
IL15RA Antibodies
IL15RA for Homo sapiens (Human)
| 產品貨號 | 產品名稱 | 種屬反應性 | 應用類型 |
|---|---|---|---|
| CSB-PA011594GA01HU | IL15RA Antibody | Human | ELISA,WB,IHC |
| CSB-PA123096 | IL15RA Antibody | Human | ELISA,WB |
| CSB-PA011216 | IL15RA Antibody | Human,Rat | WB, ELISA |
| CSB-PA971812 | IL15RA Antibody | Human,Mouse | ELISA,IHC |
IL15RA Proteins
IL15RA Proteins for Homo sapiens (Human)
| 產品貨號 | 產品名稱 | 來源 |
|---|---|---|
| CSB-BP614402HU CSB-EP614402HU-B |
Recombinant Human Interleukin-15 receptor subunit alpha (IL15RA), partial | Baculovirus In Vivo Biotinylation in E.coli |
| CSB-EP614402HU | Recombinant Human Interleukin-15 receptor subunit alpha (IL15RA), partial | E.coli |
| CSB-AP004551HU | Recombinant Human Interleukin-15 receptor subunit alpha (IL15RA), partial (Active) | Mammalian cell |
| CSB-AP004671HU | Recombinant Human Interleukin-15 & Interleukin-15 receptor subunit alpha (IL15 & IL15RA)(N120D) Heterodimer?Protein (Active) | Mammalian cell |
| CSB-MP614402HU | Recombinant Human Interleukin-15 receptor subunit alpha (IL15RA), partial | Mammalian cell |
| CSB-MP614402HUd7 | Recombinant Human Interleukin-15 receptor subunit alpha (IL15RA), partial (Active) | Mammalian cell |
| CSB-YP614402HU | Recombinant Human Interleukin-15 receptor subunit alpha (IL15RA), partial | Yeast |
IL15RA Proteins for Mus musculus (Mouse)
| 產品貨號 | 產品名稱 | 來源 |
|---|---|---|
| CSB-YP726679MO CSB-EP726679MO CSB-BP726679MO CSB-MP726679MO CSB-EP726679MO-B |
Recombinant Mouse Interleukin-15 receptor subunit alpha (Il15ra), partial | Yeast E.coli Baculovirus Mammalian cell In Vivo Biotinylation in E.coli |
| CSB-AP004801MO | Recombinant Mouse Interleukin-15 receptor subunit alpha (Il15ra), partial (Active) | Mammalian cell |
IL15RA ELISA Kit
IL15RA ELISA Kit for Homo sapiens (Human)
| 產品貨號 | 產品名稱 | 樣本類型 | 靈敏度 |
|---|---|---|---|
| CSB-EL011594HU | Human Interleukin-15 receptor subunit alpha(IL15RA) ELISA kit | serum, plasma, tissue homogenates | 7.8 pg/mL |
















